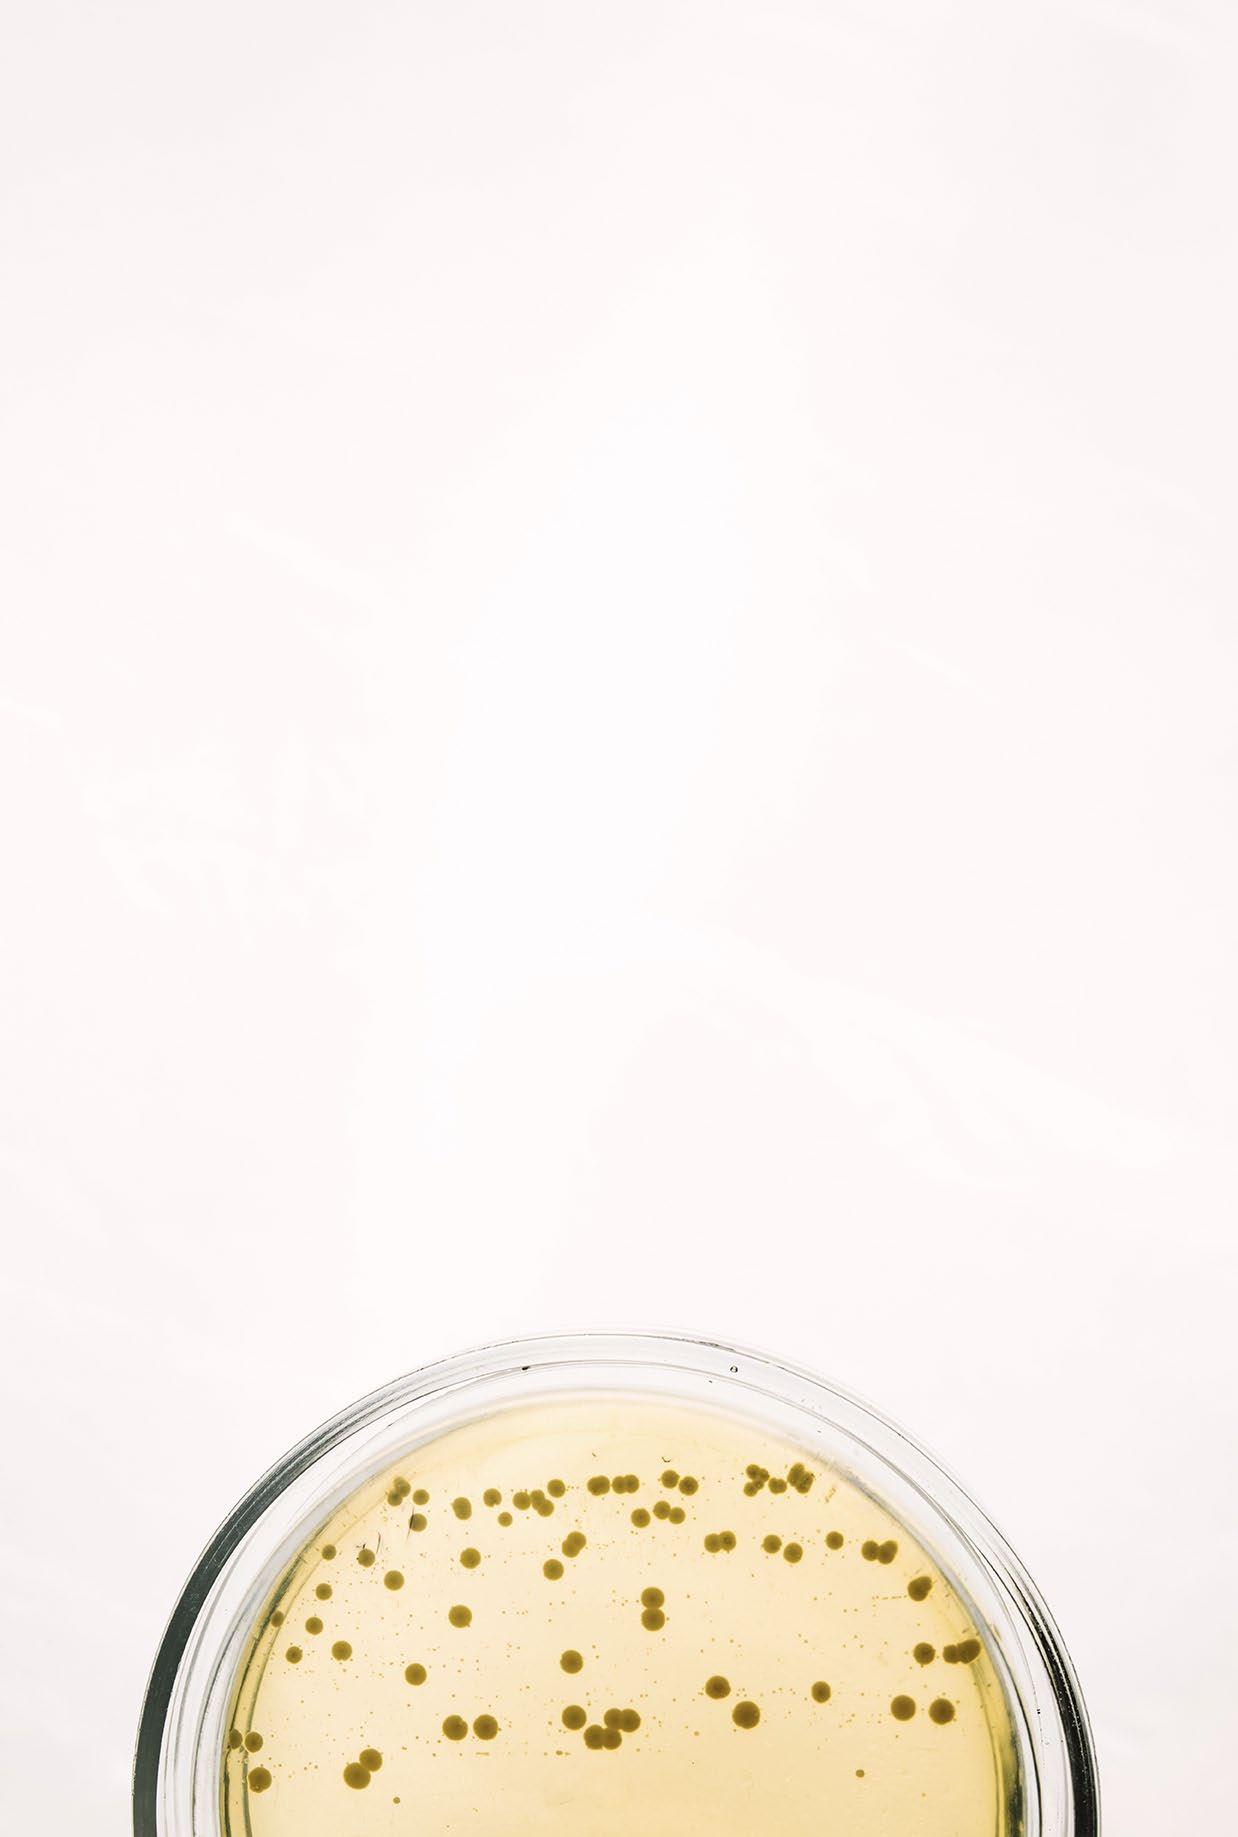

Al-Zahraa Mamdouh1 and Eman Zahran2*
1Fish Diseases Department, National Institute of Oceanography and Fisheries (NIOF), Egypt
2Department of Aquatic Animal Medicine, Faculty of Veterinary Medicine, Mansoura University, Mansoura, Egypt
*Corresponding author: emanzahran@mans.edu.eg
This review explores the complex bidirectional relationship between mycotoxins and the gut microbiome.
Mycotoxins are toxic secondary metabolites produced by fungi that contaminate food and feed, posing a health risk to humans and animals.
The gut microbiota plays a crucial role in metabolizing ingested mycotoxins through biotransformation processes.
Conversely, mycotoxins can significantly alter the composition and diversity of gut microbiota, often leading to dysbiosis.
This review examines how different mycotoxins, including aflatoxins, ochratoxins, trichothecenes, and zearalenone, interact with gut microbiota in various animal models.
It discusses the ability of certain gut microbes to degrade and detoxify mycotoxins, as well as the disruptive effects of mycotoxins on microbial communities.
Understanding these interactions is crucial for developing strategies to mitigate mycotoxin toxicity and maintain gut health.
The review highlights the need for further research to elucidate specific mechanisms of mycotoxin-microbiota interactions and explore potential interventions to enhance the protective role of gut microbiota against mycotoxins.
This integrated approach may contribute to improving food safety, animal health, and human well-being in the face of mycotoxin challenges.
Mycotoxins, microbiome, and microbiota
Mycotoxins are toxic secondary metabolites produced by filamentous fungi or molds which infect a large number of feedstuffs all over the world.
More than 400 mycotoxins have been identified (Ji, Fan et al., 2016) and the most detected ones are:
Aflatoxins (AFs)
Ochratoxin A (OTA)
Patulin (PAT)
Fumonisins (FUM)
Citrinin (CIT)
Ergot alkaloids
Trichothecenes: deoxynivalenol (DON) and T-2 toxin (T-2)
Zearalenone (ZEN)
(Anfossi, Giovannoli et al., 2016)
Mycotoxins are produced by fungal strains belonging mainly to the genus Aspergillus, Fusarium, Penicillium, Claviceps, or Alternaria (Edite Bezerra da Rocha, Freire et al., 2014) and they contaminate many crops, including maize, rice, nuts, wheat, soybean and sorghum, during different stages of food harvesting and processing (Conte, Fontanelli et al., 2020)
It was reported that 25 % or more of the worldwide agricultural crops were contaminated with mycotoxins (Eskola, Kos et al., 2020).
Food contamination with mycotoxins reduces its nutritional value and quality leading to adverse health effects and poses a health threat to human, animal, and fish (da Rocha, Freire et al., 2014, Gonçalves, Naehrer et al., 2018, Omotayo, Omotayo et al., 2019, Puri, Shingh et al., 2019, Koletsi, Schrama et al., 2021)
The term microbiome refers to the collection of all the genomes of the microorganisms present in a specific environment.
All living life including humans, animals, and plants, have microbiomes. The microbiome can be an entire organism, or a particular location on the organism.
Each organism has its own individual microbiome and there are huge variations in microbiomes between individuals.
Furthermore, organs from the same organism may have their own specific microbiome such as in the skin, lungs, and the gastrointestinal tract (Consortium 2012).
The term microbiota can be defined as a community of microorganisms living inside and benefiting a host through performing essential functions and biological processes.
The microbiota can present in many organs in humans and animals including the gut, oral cavity, vaginal tract, eyes, and skin (del Castillo, Valladares-García et al., 2018).
The interrelation between mycotoxins and the gut microbiota
The gut microbiota represents an ensemble of microorganisms including bacteria, viruses, and fungi that harbor within the GI tracts of living organisms (Liew and Mohd-Redzwan 2018)
It plays a vital role in maintaining host health and regulating various physiological functions, not only in the gastrointestinal tract, but also in other organs as well as in the immune system (Sekirov, Russell et al., 2010)
Amongst these functions, they can:
Modulate the gut epithelial barrier
Respond to inflammation
Synthesize vitamins
Ferment dietary fibers
Provide protection against pathogen colonization
(Maslowski and Mackay 2011, Kogut and Arsenault 2016)
In humans, the gastrointestinal tract contains the most abundant microbiota and it is composed of aerobic and anaerobic bacteria, archaeans, eukaryotes, and viruses.
In adults, the GIT microbiota, consists of more than 1000 different bacterial species including Bifidobacterium, Eubacterium, Clostridium, Peptococcus, Peptostreptococcus, Fermicutes and Ruminococcus, Escherichia, Enterobacter, Enterococcus, Klebsiella, Lactobacillus, Proteus, proteobacteria, Verrucomicrobia, Fusobacteria, Cyanobacteria, and Actinobacteria
The colon microbiota has a high concentration of anaerobic bacterial species that help in absorption, mucus maturation, energy conservation as well as lipid, protein, and fibre metabolism.
In ruminants, gut microbiota is involved in the fermentation of feed, contributing to 70 % of their daily energy demand by fermenting undigested dietary substrates (Yeoman and White, 2014)
Gut microbiota of ruminants includes Proteobacteria, Bacteroidetes, Firmicutes, Actinobacteria, Fusobacteria, Spirochaetes, Fibrobacteres, Tenericutes, Elusimicrobia, and Lentisphaerae.
Among them, Proteobacteria is the most predominant followed by Bacteroidetes and Firmicutes in newborn animals while in adults, Proteobacteria is usually replaced by Bacteroidetes as the most predominant phylum (Zhang, Choi et al., 2021)
In chickens, Bacteroidaceae, Ruminococcaceae, Lachnospiraceae and Clostridiaceae are the dominant bacterial strains in the gut and they represent the highest abundance in the caeca (Oakley, Lillehoj et al., 2014).
There is a bidirectional relationship between mycotoxins and gut microbiota.
Mycotoxins occur in food and feedstuff in two forms including free form and modified (masked) form.
Modified mycotoxins are formed by conjugation of the free form with polar substances in the plant or fungus (Chain 2014)
After ingestion of contaminated food, modified mycotoxins can be converted to the parent or free form by gut microbiota (Guerre, 2020) in a process called intestinal microbial deconjugation.
This usually leads to the release of their parent forms, which may induce toxicity (Payros, Alassane-Kpembi et al., 2016)
Mycotoxin-induced toxicity occurs mainly through the ingestion of contaminated food, therefore the gastrointestinal tract (GIT) is considered the first target for mycotoxins. However, it is also the first physiological barrier against them (Alassane-Kpembi, Pinton et al., 2019)
Chemical-microbial interactions can be classified into two classes:
Microbiome Modulation of Toxicity (MMT)
Toxicant Modulation of the Microbiome (TMM)
(Koontz et al., 2019)
Degradation of mycotoxins by gut microbiota (microbiome modulation of toxicity, MMT)
Gut microbiota, including bacteria, viruses and fungi, can act as a “microbial organ” which plays a vital role in the metabolism of mycotoxins ingested orally (Lyte 2010, Grenier and Applegate 2013)
Gut microbiota can biotransform mycotoxins trough bioactivation or detoxification (Liew, Nurul-Adilah et al., 2018).
Several microbial strains with the ability to metabolise mycotoxins have been isolated from animals and human gut (He, Young et al., 1992, Guan, He et al., 2009).
Biotransformation of mycotoxins by microbiota depends on:
The microbial active strains
The chemical structures of the mycotoxins
(Loi, Fanelli et al., 2017)
MMT of aflatoxins
Aflatoxins (AFs), mainly produced by Aspergillus flavus and Aspergillus parasiticus, have hepatotoxic, teratogenic, mutagenic (Kucukcakan and HayrulaiMusliu 2015, Rieswijk, Claessen et al., 2016, Rotimi, Rotimi et al., 2017), and immunosuppressive properties (Gong, Watson et al., 2016, Mohsenzadeh, Hedayati et al., 2016, Gao, Wang et al., 2023).
Based on their blue or green fluorescence under ultraviolet light, the main known aflatoxins are B1, B2, G1, and G2 (Dhanasekaran, Shanmugapriya et al., 2011)
Aflatoxin B1 (AFB1), the most commonly detected in human food and animal feed (Negash 2018), is one of the most potent hepatocarcinogens and a major contributor to occurrence of hepatocarcinoma (HCC) worldwide (Kew 2013)
Other types of aflatoxins are formed during the biotransformation and metabolism of aflatoxins in humans and animals and they include P1, Q1, B2A, and G2A (Doi, Patterson et al., 2002)
Aflatoxin M1 is a hydroxylated form of aflatoxin B1 formed in animal tissues and fluids as a metabolite of AFB1 (Neal, Eaton et al., 1998)
Furthermore, aflatoxin M2 is formed in cattle milk as a metabolite of aflatoxin B2 (Dhanasekaran, Shanmugapriya et al., 2011)
The furofuran and lactone rings are the two main toxic structural components of aflatoxins (Mishra and Das 2003)
Detoxification of aflatoxins usually involves the cleavage of the difuran ring which may results in the decrease of it’s mutagenic properties (LIU, Liang et al., 1998, Cao, Liu et al., 2011).
The degradation of aflatoxins by the gut microbiota has been investigated.
However, studies on strains directly isolated from animals gut displaying aflatoxin degrading abilities remains infrequent, despite the fact that the majority of the gut microbiome are anaerobic and theoretically, anaerobic conditions can stimulate different types of reactions which aids in mycotoxin detoxification (Adebo, Njobeh et al., 2017).
In addition, the anaerobic conditions may also possibly result in the isolation of different strains from the gut microbiome that have the ability to degrade and detoxify AFB1 (Jin, Beekmann et al., 2021)
Several bacterial strains isolated from soils and foods were found able to degrade AFs (Adebo, Njobeh et al., 2017).
These strains were isolated under aerobic conditions and incubated with aflatoxins to investigate their ability and level of degradation.
Sixteen microbial isolates from various animal faecal samples at 20 % final concentration in incubation medium were able to reduce the level of AFB1 (100 ppb) by more than 50 % after 72 h incubation at 37 °C with the bacterium Stenotrophomonas maltophilia 35–3, isolated from South American tapir faeces, to be the most effective among all isolates with a 78.7 % reduction of AFB1 levels after 72 h incubation at 37 °C (Guan, Ji et al., 2008)
A total of 139 samples from animal intestines, fermented foods and soils were collected and it was found that Bacillus subtilis ANSB060 isolated from fish gut was able to degrade 100 ng/mL of AFB1, AFM1, and AFG1 by 81.5 %, 60.0 %, and 80.7 % after 24 h incubation at 37 °C, respectively (Gao, Ma et al., 2011)
Escherichia coli CG1061 isolated from chicken cecum, was able to degrade 93.7 % of AFB1 (2.5 μg/mL) after 72 h incubation at 37 °C (Wang, Wu et al., 2019)
Bacillus licheniformis CFR1, isolated from fallow deer (Dama dama) faeces, was able to degrade 94.7 % of AFB1 (500 ng/ mL) in liquid culture media within 72 h (Rao, Vipin et al., 2017)
Myxococcus fulvus ANSM068 isolated from deer faeces, was able to degrade AFB1 by 80.7 % in liquid VY/2 medium after incubation at 30 °C for 72 h (Guan, Zhao et al., 2010)
MMT of ochratoxins
Ochratoxins are classified as ochratoxin A (OTA), produced by Aspergillus ochraceus, and ochratoxin A, B, and C, produced by other Aspergillus and Penicillium species (Marroquín-Cardona, Johnson et al., 2014).
Among them, OTA is predominantly detected in food and feed, and it is the most toxic form presenting great health risk to human and animal.
It is mainly nephrotoxic and considered as the possible cause of human Balkan endemic nephropathy (BEN) (Stiborová, Arlt et al., 2016), chronic interstitial nephropathy (CIN) (Hassen, Abid et al., 2004), and endemic porcine nephropathy in pigs (Jørgensen and Petersen 2002)
Additionally, OTA has mutagenic, teratogenic, neurotoxic, hepatotoxic and immunotoxic properties (Abrunhosa, Paterson et al., 2010)
It has also been classified as a Group 2B possible human carcinogen (Marroquín-Cardona, Johnson et al., 2014)
Ruminants and rodents are considered resistant to OTA because their microbiota has the ability to produce carboxypeptidase enzyme which can cleave the peptide bond and form less toxic OTα (Abrunhosa, Santos et al., 2006).
Several studies have investigated the degradation of OTA by gut microbiota. For example:
An early study focused in content from the four stomachs of the cow incubated with ochratoxin A at 37 °C and reported that rumina, reticula and omasa were able to degrade and convert OTA into non-toxic Otα (Hult, Teiling et al., 1976)
Ochratoxin A was degraded in to Otα and phenylalanine after incubation with intact rumen fluid and fractions of rumen protozoa and bacteria from sheep and cattle with the protozoa being more active than the bacteria (Kiessling, Pettersson et al., 1984)
Ochratoxin A was degraded in to Otα and phenylalanine when incubated anaerobically with cow rumen fluid (Müller, Lerch et al., 1998)
The digesta from the cecum and the large intestine of the rats were able to hydrolyse OTA in to Otα (Madhyastha, Marquardt et al., 1992)
Two OTA-degrading bacterial strains isolated from rumen fluid, four pure cultures obtained from pig intestine and high number of aerobic bacterial strains isolated from soil were found capable of cleaving ochratoxin A (Schatzmayr, Heidler et al., 2002)
Intestinal content isolated from swine were able to degrade OTA when incubated with 100 ppb OTA and for 6 and 12 h at 39 °C and it was reported that 20% of the OTA was detoxified, with Eubacterium biforme degrading more than 75 % of OTA in liquid media (Upadhaya, Song et al., 2012)
MMT of trichothecenes
Trichothecenes are produced by several fungal genera, including Fusarium, Microcyclospora, Myrothecium, Peltaster, Spicellum, Stachybotrys, Trichoderma and Trichothecium (Proctor, McCormick et al., 2018)
There are more than 150 toxins belonging to the trichothecenes group including deoxynivalenol (DON), nivalenol (NIV), T-2 toxin, HT-2 toxin and diacetoxyscirpenol (DAS) (Yang, Wang et al., 2015).
Among them, DON is the most prevalent contaminant in animal and human food (Payros, Dobrindt et al., 2017, Wang, Zhang et al., 2019). In addition to DON, cereal grains and feeds are often co-contaminated with modified forms of DON including:
3-acetyldeoxynivalenol (3-Ac-DON)
15-acetyldeoxynivalenol (15-Ac-DON)
Deoxynivalenol-3-β-d-glucopyranoside (D3G)
Modified forms of DON can be deconjugated to DON by the gut microbiota in different host species like cows, pigs and chickens causing increased exposure to DON (Payros, Alassane-Kpembi et al., 2016)
Clinical manifestations after DON acute exposure in humans and animals usually involve adverse effects on the GIT including nausea, vomiting, GI upset, dizziness, diarrhea and headache (Pestka 2010, Pinton, Tsybulskyy et al., 2012)
It can cause weight loss and the refusal to eat when ingested by swine and other animals in small doses (vomitoxin or food refusal factor) (da Rocha, Freire et al., 2014).
DON can cause intestinal pathological lesions in humans and animals including lesions, cell proliferation and differentiation alterations, and disturbance of the barrier function (Payros, Alassane-Kpembi et al., 2016)
In addition to GIT toxicity, DON can cause immunotoxicity (Liao, Peng et al., 2018), hematotoxicity (Parent-Massin 2004), and neurotoxicity (Zhang, You et al., 2020)
Modified acetylated forms of DON are reported to induce intestinal and immune toxicity (Pinton, Tsybulskyy et al., 2012), especially 15-Ac-DON, which has been reported to be more toxic than DON and 3-Ac-DON.
According to their potency to cause toxic effects in jejunal explants of pigs exposed to DON for short term duration, DON and its modified forms were ranked in the following order: 3-Ac-DON = DON < 15-Ac-DON (Pinton, Tsybulskyy et al., 2012)
Acetylated DON forms were reported to produce IL-8 in human Caco-2 cells and it was found that their toxicity potency was as follows: 3-Ac-DON < DON <15-Ac-DON (Kadota, Furusawa et al., 2013).
Several studies have reported bacterial strains and gut microbiomes isolated from animal and human faecal samples, capable of transforming DON and modified DON.
Microbiota from rumen fluid transformed DON and 3-Ac-DON to DOM-1 at degradation levels of 89 % within 24 hours and 100 % within 48 hours (King, McQueen et al., 1984).
DON was transformed under anaerobic conditions to DOM-1 (25 mg/L, 48 h) by BBSH 797 Eubacterium found in rumen fluid (Fuchs, Binder et al., 2002)
Microbiota and pure cultures of microbial isolates from chicken intestine was found able to degrade 3-Ac-DON, 15-Ac-DON, and DON by deepoxidation and/or deacetylation (Young, Zhou et al., 2007).
MMT of zearalenone
ZEN is a non-steroidal estrogenic compound synthesized mainly by Fusarium graminearum and by other Fusarium genera including Fusarium culmorum and Fusarium cerealis (De Boevre, Di Mavungu et al., 2012, Taheur, Fedhila et al., 2017).
Zearalenone has genotoxic (Taranu, Braicu et al., 2015, Braicu, CojocneanuPetric et al., 2016), immunotoxic (Hueza, Raspantini et al., 2014, Assumaidaee, Ali et al., 2020), teratogenic, carcinogenic (Abassi, Ayed-Boussema et al., 2016), hematotoxic and hepatotoxic properties (Bai, Sun et al., 2018), but its toxicity to humans and animals arises mainly from its xenosteroidal activities.
DON was transformed by chicken gut microbiota through deepoxidation under anaerobic conditions to DOM-1 at 99 % after 72 hours (He, Young et al., 1992)
In a more recent study, caecum content of chicken intestine was able to completely transform DON to DOM-1 through deepoxidation after in vitro anaerobic incubation for 24 h while duodenal microbiota was able to give 100 % deacetylation of 3-Ac-DON within 24 h (Jin, Fall et al., 2021)
Microbiota in pig gut transformed DON under anaerobic conditions in to DOM-1 by 99 % after 24 hours (Kollarczik, Gareis et al., 1994)
The chemical structure of ZEN is similar to natural estrogen, 17β-estradiol.
Therefore, ZEN and its analogues can either activate the estrogen receptors or compete with their receptors, leading to estrogenic or antiestrogenic effects (Wang, Zheng et al., 2014, Kowalska, Habrowska-Górczyńska et al., 2016).
Additionally, it exerts its action by acting as an endocrine-disrupting compound (EDC) (Rogowska, Pomastowski et al., 2019)
After ingestion by human and animals, ZEN is metabolised by the gut microbiota into its analogues
α- and β-zearalenol (α-ZEL, β-ZEL) and to a lesser extent into α- and β-zearalanol (α-ZAL, β-ZAL).
After absorption, intestinal and liver cells further metabolise ZEN and its analogues into glucuronide conjugates.
α-ZEL thas more estrogenic potency than ZEN and β-ZEL, whereas the glucuronide conjugates have less estrogen-like activity than ZEN (Frizzell, Uhlig et al., 2015)
Therefore, the formation of α-ZEL is considered bioactivation while the formation of β-ZEL is considered detoxification of ZEN.
Several studies have reported gut microbiomes of human and animals that can act on ZEN and its analogues.
Lactobacillus mucosae lm4208 isolated from the rumen degraded 69 % of 10 μg/mL ZEN after 24 h culturing, but no degradation products were observed. The authors speculated that the ZEN reduction was due to adsorption of ZEN to sites on the cell surface (Long Miao, Li Peng et al., 2012)
Bacterial strain Pseudomonas otitidis TH-N1 from cow rumen degraded ZEN as a sole source of carbon and energy with 69 % conversion at 2 μg/mL ZEN after 168 h incubation (Tan, Zhang et al., 2015).
Lysinibacillus sp. strain isolated from chicken GI digesta was able to eliminate ZEN in Luria-Bertani medium at 32 μg/mL within 48 h (Wang, Yang et al., 2018).
More than 90 % of the zearalenone was degraded to α- and β-zearalenol after incubation with intact rumen fluid and fractions of rumen protozoa and bacteria of cattle and sheep (Kiessling, Pettersson et al., 1984).
ZEN was degraded under anaerobic conditions into α-ZEL and unidentified metabolite by pig intestinal contents (Kollarczik, Gareis et al., 1994) and in another study with 17–52 % degradation rate at 10 μmol/mL after 24 h (Kollarczik, Gareis et al., 1994)
Modulation of gut microbiota by mycotoxins (Toxicant Modulation of the Microbiome, TMM)
The GIT is the main route for the entry of mycotoxins to animals due to ingestion of contaminated food and feed, therefore their concentration could be higher in the GIT than in other organs (Grenier and Applegate 2013).
The relationship between mycotoxins and microbiota is bidirectional.
The gut microbiota can degrade and metabolise mycotoxins. However, at the same time, mycotoxins can induce severe damage to the gut microbiota of humans and animals.
They can cause a wide range of toxicities and disturb gut homeostasis by inducing intestinal damage, inflammation and gut microbiota dysbiosis (Elmassry, Zayed et al., 2022). They also can modulate gut microbiota and affect their abundance and activity.
The effect of mycotoxins on the gut microorganisms consists primarily of alterations in the digestive tract microbial population.
by aflatoxins
Exposure of sheep to AFB1 orally at a single dose of 1 mg/kg body weight significantly increased Firmicutes/ ratio and decreased the abundance of Butyrivibrio. microbiota have been proven to affect the quality of the sheep mutton (Cao, Lin et al., 2021).
Dietery exposure of kunming mice to 0.75 mg/kg AFB1 for 54 days significantly increased the relative abundance of Clostridia UCG 014 and Firmicutes /Bacteroidetes significantly decreased the relative abundance of Lachnospiraceae NK4A136 group (Xu, Dong et al., 2023).
These modulations can occur at the species, genus, and phylum levels. In addition, these modifications can be due to the direct effect of mycotoxins and their antimicrobial properties or it can be secondary to the toxic consequences of mycotoxins on the intestinal cells, as well as the release of antimicrobial compounds (Mamdouh and Zahran)
There are several experimental studies regarding modulation of gut microbiota by different mycotoxins.
TMM
Oral gavage of mice with 200 μg/kg/d AFB1 for 28 days increased relative expression of Bacteroidetes at phylum-level and altered the relative expression of Staphylococcus and Muribaculaceae at genus-level. In addition, LefSe analysis proved that the relative expression level of Bacilli, Staphylococcaceae, and other microbiota was significantly increased after AFB1 exposure which finally had a relation to induced testicular damage to the mice (Zhang, Ma et al., 2024)
The abundances of intestinal microbiota Staphylococcusxylosu, Esherichia coli-g, and Escherichia-Shigella were significantly increased and the abundance of Lactobacillus aviarius was significantly decreased in broilers fed with 40 μg/kg AFB1 for 21 days (Guo, Wang et al., 2023)
AFB1 at a dose of 100 μg/kg body weight, dissolved in 4 % ethanol solution was injected into the ingluvies of broiler chickens for 7 days induced significant decrease in the abundance of Firmicutes and Proteobacteria and the Firmicutes/Bacteroidetes (F/B) ratio and significant increase in the abundance of Tenericutes and Verrucomicrobia while at the genus level Lachnospiraceae, Lactobacillaceae, Lactobacillus, Lactobacillus_helveticus, Ruminococcus and Blautia were significantly increased. In addition, it was reported that AFB1 mainly disrupted the abundance of bacteria associated with bile acid metabolism, where it significantly decreased the relative abundance of Faecalibacterium and Subdoligranulum and increased the relative abundance of Ruminococcus (Huang, Lin et al., 2023)
Compound dietary exposure of broilers to 500 μg/kg ZEN + 50 μg/kg AFB1 for 21 days significantly increased the abundance jejunal microbiota (uncultured_bacterium_g_Romboutsia, uncultured_bacterium_g_Terrisporobacter, Clostridium_ sensu_stricto_1, uncultured_bacterium_g_Lactobacillus, uncultured_bacterium_g_Turicibacter, bacterium_GC452011) and significantly decreased the relative abundance of Lactobacillus aviaries (Chang, Wang et al., 2020)
TMM by ochratoxins
Rats exposed to OTA at concentrations of 70 and 210 μg/kg body weight by gavage for 28 days suffered from decreased diversity of the gut microbiota, increased relative abundance of Lactobacillus and induced multiple changes in functional genes of gut microbiota including signal transduction, carbohydrate transport, transposase, amino acid transport system (Guo, Huang et al., 2014)
Oral sub-chronic exposure of mice to 0.21 and 0.5 mg/kg body weight OTA for 28 days induced marked changes in gut microbial community structure, including the decrease in the diversity of feacal microbiota and the relative abundance of Firmicutes, as well as increase in the relative abundance of Bacteroidetes at the phylum level while at the family level, six bacterial families (unclassified Bacteroidales, Porphyromonadaceae, unclassified Cyanobacteria, Streptococcaceae, Enterobacteriaceae, Ruminococcaceae) were significantly altered by OTA exposure (Izco, Vettorazzi et al., 2021)
Dietary exposure of rats to 250 μg/kg BW OTA containing 0.1 M sodium bicarbonate through gavage once daily for 21 days significantly reduced microbial diversity and abundance which was indicated by decreased Simpson, ACE, Chao1, and Shannon indexes while at the phylum level, OTA significantly reduced relative abundance of Bacteroidetes and significantly increased Firmicutes (Zhang, Yan et al., 2021)
Analysis of alpha diversity of intestinal microbiota of broilers exposed to 50 μg/kg BW OTA for 21 days revealed that the ACE, Chao, and Shannon indexes were significantly decreased indicating that that OTA significantly reduced the number (abundance) of microorganisms in the caecum and species diversity of the microbial community. Also, at the genus level, the abundance of Clostridiales vadin BB6 was significantly decreased and the abundance of Ruminococcaceae was significantly increased (Yang, Li et al., 2020)
Ducklings exposed to OTA at a dosage of 500 μg/ kg body weight with 0.1 M sodium bicarbonate once a day for three weeks by oral gavage showed that the relative abundance of Bacteroidetes was significantly increased and Firmicutes was significantly decreased while the ratio of relative abundance of Bacteroidetes/Firmicutes was significantly increased. In addition, the relative abundance of lipopolysaccharide producing bacteria including bacteroides uniformis and turicibacter sanguinis were significantly increased indicating that these microbiota were associated with liver damage caused by OTA (Xia, Yang et al., 2021)
ACE and Shannon indexes revealed that OTA significantly reduced the richness and diversity of cecum microbiota in ducks exposed to oral gavage of OTA at a dose of 235 μg/kg body weight for 2 weeks. It also increased the relative abundance of Bacteroidetes at the phylum level and Bacteroides at the genus level. In addition, OTA significantly increased the relative abundance of LPS-producing Bacteroides (Wang, Zhai et al., 2019)
TMM by deoxynivalenol
Dietary exposure of Hy-line brown laying hens to 10 mg/kg bw DON daily for 6 weeks significantly decreased the diversity of gut microbiota indicated by significantly decreased Chao and ACE indexes. Additionally, at the phylum level, the relative abundances of Firmicutes and Actinobacteria were significantly reduced while the relative abundance of Bacteroidetes, Proteobacteria, and Spirochaetes was significantly increased (Zhai, Qiu et al., 2022)
Chickens fed diets contaminated with 2.5, 5, and 10 mg/kg DON for 5 weeks showed a significantly decreased ceacal species richness and evenness based on the Chao 1 and Shannon indexes. Additionally, the phyla Firmicutes significantly increased and Proteobacteria significantly decreased with increasing DON-concentrations. Also, Within the Firmicutes, DON decreased the relative abundance of Oscillospira, Clostridiaceae genus, Clostridium, and Ruminococcaceae genus 2 whereas it increased Clostridiales genus 2. Moreover, increasing DON levels linearly decreased the abundance of Enterobacteriaceae genus and an Escherichia/Shigella-OTU (Lucke, Böhm et al., 2018)
Chronic exposure of mice to 10 μg/kg bw/day of DON diluted in their drinking water for 9 months completely altered the composition of their gut microbiota where at the phylum and family level, DON significantly increased the representation of Deferribacteres, Proteobacteria, TM7, Verrucomicrobia, Tenericutesand Cyanobacteria and the proportion of Odoribacteraceae, Enterobacteriaceae, Deferribacteraceae, F16, Turicibacteraceae, and Helicobacteraceae while it significantly decreased the abundance of Actinobacteria and Bacteroidetes and the proportion of Coriobacteriaceae, S-24-7, and Streptococcaceae. Furthermore, at the genus level, DON significantly elevated the proportions of Odoribacter, Mucispirillum and Helicobacter, and decreased proportions of Adlercreutzia, Dorea, Bifidobacterium and Streptococcus (Vignal, Djouina et al., 2018)
Gut microbiota of mice was modulated after exposure to 25 μg/kg bw/day DON for 30 days through oral gavage where at the phyla level, Proteobacteria and Verrucomicrobia were significantly increased. Additionally, the alpha diversity based on Shannon and Chao 1 indexes was decreased indicating significantly decreased diversity and richness of gut microbiota. At the genus level, LEfSe algorithm and Kruskal Wallis test revealed that Parabacteroides and Enterobacter were the most abundant while Lactobacillus, Odoribacter and Lachnospiracea incertae sedis showed the greatest decline (Peng, Liao et al., 2019)
Exposure of piglets to 1040 μg/kg DON for 28 days significantly increased the relative abundances of uncultured_bacterium_f_Muribaculaceae, Blautia and Megasphaera and significantly decreased Subdoligranulum and Clostridium_ sensu_stricto_1 (Xu, Chang et al., 2023)
Dietary exposure of piglets to 1000.6 μg/kg DON individually or DON (1007.5) combined with 265.4 μg/kg ZEN for 42 days significantly increased the abundance of E. coli and significantly decreased the abundance of Lactobacillus and Bifidobacterium (Jia, Liu et al., 2020). Diets of weaned piglets contaminated with 208 μg/kg and 3.11 mg/kg DON significantly increased the Shannon index of gut microbiota composition where it significantly decreased the relative abundances of the phyla Phascolarctobacterium and Subdoligranulum, Collinsella and Faecalibacterium, while increasing the relative abundances of Ruminococcus_2, Rikenellaceae_RC9_gut_group, Parabacteroides and Methanobrevibacter (Bai, Ma et al., 2022)
TMM by zearalenone
The addition of 250 μg/kg ZEN and 750 μg/kg ZEN to laying hens diets significantly reduced the number and diversity caecum bacteria where it significantly increased the relative abundance of norank_f__ Muribaculaceae in a dose-dependent manner and significantly decreased the relative abundance of Candidatus_Saccharimonas (Yuan, Li et al., 2022).
Weaned rabbits orally given different concentrations of ZEN (400, 800, and 1600 μg/kg) for 28 days showed significantly decreased abundance of Actinobacteria and significantly increased abundance of Cyanobacteria, Synergistetes, and Proteobacteria. At the genus level, there were declines in the abundance of Adlercreutzia, Blautia, Desulfitobacter, Lactobacillus, Oxalobacter, and p-75-a5 (Li, Yang et al., 2018)
Rats exposed to ZEN at dosage level of 5.0 mg/kg showed a significantly increased Bacteroidetes while at dosage level of 0.2 mg/kg showed significantly increased Ruminiclostridium_9 and Parabacteroides (Zhang, Zhang et al., 2020)
ZEN exposure in pigs significantly reduced the richness of caecal and colonic microbiota and induced alterations of α and β diversity in the jejunum and ileum where it significantly increased the abundance of Bacteroidetes, Actinobacteria, Firmicutes, Cyanobacteria. Additionally, ZEN exposure disturbed the reproductive-immune axis in pigs through altering the gut microbiota where it decreased butyrate production by inhibiting butyrateproducing bacteria including Ruminococcaceae, and Erysipelotrichaceae and stimulated LPS production by increasing LPS-producing bacteria such as Clostridiaceae (Wang, Fu et al., 2022)
Dietary exposure of piglets to 269.1 μg/kg ZEN individually or ZEN (265.4 μg/kg) combined with 1007.5 μg/kg DON for 42 days significantly increased the abundance of E. coli and significantly decreased the abundance of Lactobacillus and Bifidobacterium (Jia, Liu et al., 2020) .
CONCLUSIONS
In conclusion, this review highlights the complex and bidirectional relationship between mycotoxins and the gut microbiome.
Mycotoxins can significantly alter the composition and diversity of gut microbiota in humans and animals, often leading to dysbiosis and associated health issues.
Conversely, certain gut microbes have demonstrated the ability to degrade and detoxify various mycotoxins, potentially mitigating their toxic effects
The interactions between mycotoxins and gut microbiota are influenced by factors such as mycotoxin type and concentration, host species, and environmental conditions.
Understanding these interactions is crucial for developing strategies to mitigate mycotoxin toxicity and maintain gut health.
Future research should focus on:
Elucidating the specific mechanisms of mycotoxin-microbiota interactions.
Identifying beneficial microbes for mycotoxin detoxification.
Exploring potential probiotic or prebiotic interventions to enhance the gut microbiome’s protective role against mycotoxins.
Additionally, more studies are needed to investigate the long-term effects of chronic, low-dose mycotoxin exposure on gut microbiota and overall health.
As mycotoxin contamination remains a significant global food safety concern, integrating gut microbiome research into mycotoxicology could lead to novel approaches for risk assessment and mitigation strategies.
This holistic approach may contribute to improving food safety, animal health, and human well-being in the face of mycotoxin challenges.
REFERENCES
Abassi, H., I. Ayed-Boussema, S. Shirley, S. Abid, H. Bacha and O. Micheau (2016). “The mycotoxin zearalenone enhances cell proliferation, colony formation and promotes cell migration in the human colon carcinoma cell line HCT116.” Toxicology letters 254: 1-7.
Abrunhosa, L., R. R. Paterson and A. Venâncio (2010). “Biodegradation of ochratoxin A for food and feed decontamination.” Toxins 2(5): 1078-1099.
Abrunhosa, L., L. Santos and A. Venâncio (2006). “Degradation of ochratoxin A by proteases and by a crude enzyme of Aspergillus niger.” Food Biotechnology 20(3): 231-242.
Adebo, O., P. Njobeh, S. Gbashi, O. Nwinyi and V. Mavumengwana (2017). “Review on microbial degradation of aflatoxins.” Critical reviews in food science and nutrition 57(15): 3208-3217.
Alassane-Kpembi, I., P. Pinton and I. P. Oswald (2019). Effects of Mycotoxins on the Intestine, MDPI. 11: 159.
Anfossi, L., C. Giovannoli and C. Baggiani (2016). “Mycotoxin detection.” Current opinion in biotechnology 37: 120-126.
Assumaidaee, A. A., N. M. Ali and S. W. Ahmed (2020). “Zearalenone Mycotoxicosis: Pathophysiology and Immunotoxicity.” The Iraqi Journal of Veterinary Medicine 44(1): 29-38.
Bai, X., C. Sun, J. Xu, D. Liu, Y. Han, S. Wu and X. Luo (2018). “Detoxification of zearalenone from corn oil by adsorption of functionalized GO systems.” Applied surface science 430: 198-207.
Bai, Y., K. Ma, J. Li, Z. Ren, J. Zhang and A. Shan (2022). “Lactobacillus rhamnosus GG ameliorates DON-induced intestinal damage depending on the enrichment of beneficial bacteria in weaned piglets.” Journal of Animal Science and Biotechnology 13(1): 90.
Braicu, C., R. Cojocneanu-Petric, A. Jurj, D. Gulei, I. Taranu, A. M. Gras, D. E. Marin and I. Berindan-Neagoe (2016). “Microarray based gene expression analysis of Sus Scrofa duodenum exposed to zearalenone: significance to human health.” BMC genomics 17(1): 1-10.
Cao, H., D. Liu, X. Mo, C. Xie and D. Yao (2011). “A fungal enzyme with the ability of aflatoxin B1 conversion: Purification and ESI-MS/MS identification.” Microbiological Research 166(6): 475-483.
Cao, Q.-q., L.-x. Lin, T.-t. Xu, Y. Lu, C.-d. Zhang, K. Yue, S.-c. Huang, H.-j. Dong and F.-c. Jian (2021). “Aflatoxin B1 alters meat quality associated with oxidative stress, inflammation, and gut-microbiota in sheep.” Ecotoxicology and Environmental Safety 225: 112754.
Chain, E. P. o. C. i. t. F. (2014). “Scientific Opinion on the risks for human and animal health related to the presence of modified forms of certain mycotoxins in food and feed.” EFSA Journal 12(12): 3916.
Chang, J., T. Wang, P. Wang, Q. Yin, C. Liu, Q. Zhu, F. Lu and T. Gao (2020). “Compound probiotics alleviating aflatoxin B1 and zearalenone toxic effects on broiler production performance and gut microbiota.” Ecotoxicology and Environmental Safety 194: 110420.
Consortium, H. M. P. (2012). “Structure, function and diversity of the healthy human microbiome.” nature 486(7402): 207-214.
Conte, G., M. Fontanelli, F. Galli, L. Cotrozzi, L. Pagni and E. Pellegrini (2020). “Mycotoxins in feed and food and the role of ozone in their detoxification and degradation: An update.” Toxins 12(8): 486.
da Rocha, M. E. B., F. d. C. O. Freire, F. E. F. Maia, M. I. F. Guedes and D. Rondina (2014). “Mycotoxins and their effects on human and animal health.” Food Control 36(1): 159-165.
De Boevre, M., J. D. Di Mavungu, S. Landschoot, K. Audenaert, M. Eeckhout, P. Maene, G. Haesaert and S. De Saeger (2012). “Natural occurrence of mycotoxins and their masked forms in food and feed products.” World Mycotoxin Journal 5(3): 207-219.
del Castillo, M. C. M., J. Valladares-García and J. Halabe-Cherem (2018). “Microbioma humano.” Revista de la Facultad de Medicina UNAM 61(6): 7-19.
Dhanasekaran, D., S. Shanmugapriya, N. Thajuddin and A. Panneerselvam (2011). “Aflatoxins and aflatoxicosis in human and animals.” Aflatoxins-Biochemistry and Molecular Biology 10(22717): 221-254.
Doi, A. M., P. E. Patterson and E. P. Gallagher (2002). “Variability in aflatoxin B1–macromolecular binding and relationship to biotransformation enzyme expression in human prenatal and adult liver.” Toxicology and applied pharmacology 181(1): 48-59.
Edite Bezerra da Rocha, M., F. d. C. O. Freire, F. Erlan Feitosa Maia, M. Izabel Florindo Guedes and D. Rondina (2014). “Mycotoxins and their effects on human and animal health.” Food Control 36(1): 159-165.
Elmassry, M. M., A. Zayed and M. A. Farag (2022). “Gut homeostasis and microbiota under attack: Impact of the different types of food contaminants on gut health.” Critical Reviews in Food Science and Nutrition 62(3): 738-763.
Eskola, M., G. Kos, C. T. Elliott, J. Hajšlová, S. Mayar and R. Krska (2020). “Worldwide contamination of food-crops with mycotoxins: Validity of the widely cited ‘FAO estimate’of 25%.” Critical reviews in food science and nutrition 60(16): 2773-2789.
Frizzell, C., S. Uhlig, C. O. Miles, S. Verhaegen, C. T. Elliott, G. S. Eriksen, M. Sørlie, E. Ropstad and L. Connolly (2015). “Biotransformation of zearalenone and zearalenols to their major glucuronide metabolites reduces estrogenic activity.” Toxicology In Vitro 29(3): 575-581.
Fuchs, E., E. Binder, D. Heidler and R. Krska (2002). “Structural characterization of metabolites after the microbial degradation of type A trichothecenes by the bacterial strain BBSH 797.” Food Additives & Contaminants 19(4): 379-386.
Gao, X., Q. Ma, L. Zhao, Y. Lei, Y. Shan and C. Ji (2011). “Isolation of Bacillus subtilis: screening for aflatoxins B 1, M 1, and G 1 detoxification.” European Food Research and Technology 232: 957-962.
Gao, Y.-N., Z.-W. Wang, X. Yang, J.-Q. Wang and N. Zheng (2023). “Aflatoxin M1 and ochratoxin A induce a competitive endogenous RNA regulatory network of intestinal immunosuppression by whole-transcriptome analysis.” Science of The Total Environment 854: 158777.
Gonçalves, R. A., K. Naehrer and G. A. Santos (2018). “Occurrence of mycotoxins in commercial aquafeeds in Asia and Europe: a real risk to aquaculture?” Reviews in Aquaculture 10(2): 263-280.
Gong, Y. Y., S. Watson and M. N. Routledge (2016). “Aflatoxin exposure and associated human health effects, a review of epidemiological studies.” Food safety 4(1): 14-27.
Grenier, B. and T. J. Applegate (2013). “Modulation of intestinal functions following mycotoxin ingestion: Meta-analysis of published experiments in animals.” Toxins 5(2): 396-430.
Guan, S., J. He, J. C. Young, H. Zhu, X.-Z. Li, C. Ji and T. Zhou (2009). “Transformation of trichothecene mycotoxins by microorganisms from fish digesta.” Aquaculture 290(3-4): 290-295.
Guan, S., C. Ji, T. Zhou, J. Li, Q. Ma and T. Niu (2008). “Aflatoxin B1 degradation by Stenotrophomonas maltophilia and other microbes selected using coumarin medium.” International journal of molecular sciences 9(8): 1489-1503.
Guan, S., L. Zhao, Q. Ma, T. Zhou, N. Wang, X. Hu and C. Ji (2010). “In vitro efficacy of Myxococcus fulvus ANSM068 to biotransform aflatoxin B1.” International Journal of Molecular Sciences 11(10): 4063-4079.
Guerre, P. (2020). Mycotoxin and Gut Microbiota Interactions. Toxins, 12 (12), 769.
Guo, H., P. Wang, C. Liu, J. Chang, Q. Yin, L. Wang, S. Jin, Q. Zhu and F. Lu (2023). “Compound mycotoxin detoxifier alleviating aflatoxin B1 toxic effects on broiler growth performance, organ damage and gut microbiota.” Poultry Science 102(3): 102434.
Guo, M., K. Huang, S. Chen, X. Qi, X. He, W.-H. Cheng, Y. Luo, K. Xia and W. Xu (2014). “Combination of Metagenomics and Culture-Based Methods to Study the Interaction Between Ochratoxin A and Gut Microbiota.” Toxicological Sciences 141(1): 314-323.
Hassen, W., S. Abid, A. Achour, E. Creppy and H. Bacha (2004). “Ochratoxin A and β2-microglobulinuria in healthy individuals and in chronic interstitial nephropathy patients in the centre of Tunisia: a hot spot of Ochratoxin A exposure.” Toxicology 199(2-3): 185-193. He, P., L. Young and C. Forsberg (1992). “Microbial transformation of deoxynivalenol (vomitoxin).” Applied and environmental microbiology 58(12): 3857-3863.
Huang, S., L. Lin, S. Wang, W. Ding, C. Zhang, A. Shaukat, B. Xu, K. Yue, C. Zhang and F. Liu (2023). “Total flavonoids of rhizoma drynariae mitigates aflatoxin B1-induced liver toxicity in chickens via microbiota-gut-liver axis interaction mechanisms.” Antioxidants 12(4): 819.
Hueza, I. M., P. C. F. Raspantini, L. E. R. Raspantini, A. O. Latorre and S. L. Górniak (2014). “Zearalenone, an estrogenic mycotoxin, is an immunotoxic compound.” Toxins 6(3): 1080-1095.
Hult, K., A. Teiling and S. Gatenbeck (1976). “Degradation of ochratoxin A by a ruminant.” Applied and Environmental Microbiology 32(3): 443-444.
Izco, M., A. Vettorazzi, M. de Toro, Y. Sáenz and L. Alvarez-Erviti (2021). “Oral sub-chronic ochratoxin a exposure induces gut microbiota alterations in mice.” Toxins 13(2): 106.
Ji, C., Y. Fan and L. Zhao (2016). “Review on biological degradation of mycotoxins.” Animal nutrition 2(3): 127-133.
Jia, R., W. Liu, L. Zhao, L. Cao and Z. Shen (2020). “Low doses of individual and combined deoxynivalenol and zearalenone in naturally moldy diets impair intestinal functions via inducing inflammation and disrupting epithelial barrier in the intestine of piglets.” Toxicology letters 333: 159-169.
Jin, J., K. Beekmann, E. Ringø, I. M. Rietjens and F. Xing (2021). “Interaction between food-borne mycotoxins and gut microbiota: A review.” Food Control 126: 107998.
Jin, J., M. Fall, Q. Liu, I. M. Rietjens and F. Xing (2021). “Comparative microbial conversion of deoxynivalenol and acetylated deoxynivalenol in different parts of the chicken intestine as detected in vitro and translated to the in vivo situation.” Journal of Agricultural and Food Chemistry 69(50): 15384-15392.
Jørgensen, K. and A. Petersen (2002). “Content of ochratoxin A in paired kidney and meat samples from healthy Danish slaughter pigs.” Food Additives & Contaminants 19(6): 562-567.
Kadota, T., H. Furusawa, S. Hirano, O. Tajima, Y. Kamata and Y. Sugita-Konishi (2013). “Comparative study of deoxynivalenol, 3-acetyldeoxynivalenol, and 15-acetyldeoxynivalenol on intestinal transport and IL-8 secretion in the human cell line Caco-2.” Toxicology in Vitro 27(6): 1888-1895.
Kew, M. C. (2013). “Aflatoxins as a cause of hepatocellular carcinoma.” Journal of Gastrointestinal & Liver Diseases 22(3).
Kiessling, K.-H., H. Pettersson, K. Sandholm and M. Olsen (1984). “Metabolism of aflatoxin, ochratoxin, zearalenone, and three trichothecenes by intact rumen fluid, rumen protozoa, and rumen bacteria.” Applied and environmental microbiology 47(5): 1070-1073.
King, R. R., R. E. McQueen, D. Levesque and R. Greenhalgh (1984). “Transformation of deoxynivalenol (vomitoxin) by rumen microorganisms.” Journal of Agricultural and Food Chemistry 32(5): 1181-1183.
Kogut, M. H. and R. J. Arsenault (2016). Gut health: The new paradigm in food animal production, Frontiers Media SA. 3: 71.
Koletsi, P., J. W. Schrama, E. A. Graat, G. F. Wiegertjes, P. Lyons and C. Pietsch (2021). “The Occurrence of Mycotoxins in Raw Materials and Fish Feeds in Europe and the Potential Effects of Deoxynivalenol (DON) on the Health and Growth of Farmed Fish Species—A Review.” Toxins 13(6): 403.
Kollarczik, B., M. Gareis and M. Hanelt (1994). “In vitro transformation of the Fusarium mycotoxins deoxynivalenol and zearalenone by the normal gut microflora of pigs.” Natural toxins 2(3): 105-110.
Kowalska, K., D. E. Habrowska-Górczyńska and A. W. Piastowska-Ciesielska (2016). “Zearalenone as an endocrine disruptor in humans.” Environmental toxicology and pharmacology 48: 141-149.
Kucukcakan, B. and Z. Hayrulai-Musliu (2015). “Challenging role of dietary aflatoxin B1 exposure and hepatitis B infection on risk of hepatocellular carcinoma.” Open access Macedonian journal of medical sciences 3(2): 363-369.
Li, P., S. Yang, X. Zhang, S. Huang, N. Wang, M. Wang, M. Long and J. He (2018). “Zearalenone changes the diversity and composition of caecum microbiota in weaned rabbit.” BioMed Research International 2018(1): 3623274.
Liao, Y., Z. Peng, L. Chen, A. K. Nüssler, L. Liu and W. Yang (2018). “Deoxynivalenol, gut microbiota and immunotoxicity: A potential approach?” Food and Chemical Toxicology 112: 342-354.
Liew, W.-P.-P. and S. Mohd-Redzwan (2018). “Mycotoxin: Its impact on gut health and microbiota.” Frontiers in cellular and infection microbiology 8: 60.
Liew, W.-P.-P., Z. Nurul-Adilah, L. T. Than and S. Mohd-Redzwan (2018). “The binding efficiency and interaction of Lactobacillus casei Shirota toward aflatoxin B1.” Frontiers in microbiology 9: 1503.
LIU, D. L., R. Liang, D. S. YAO, L. Q. GU, L. Ma and W. Q. CHEN (1998). “Armillariella tabescen Enzymatic Detoxification of Aflatoxin B1 (Part II) a.” Annals of the New York Academy of Sciences 864(1): 586-591.
Loi, M., F. Fanelli, V. C. Liuzzi, A. F. Logrieco and G. Mulè (2017). “Mycotoxin biotransformation by native and commercial enzymes: Present and future perspectives.” Toxins 9(4): 111.
Long Miao, L. M., L. P. Li Peng, Z. W. Zhang WenKui, L. X. Li XiaoBing, Z. Y. Zhang Yi, W. Z. Wang Zhe and L. G. Liu GuoWen (2012). “Removal of zearalenone by strains of Lactobacillus sp. isolated from rumen in vitro.”
Lucke, A., J. Böhm, Q. Zebeli and B. U. Metzler-Zebeli (2018). “Dietary deoxynivalenol contamination and oral lipopolysaccharide challenge alters the cecal microbiota of broiler chickens.” Frontiers in Microbiology 9: 804.
Lyte, M. (2010). “The microbial organ in the gut as a driver of homeostasis and disease.” Medical hypotheses 74(4): 634-638.
Madhyastha, M., R. Marquardt and A. Frohlich (1992). “Hydrolysis of ochratoxin A by the microbial activity of digesta in the gastrointestinal tract of rats.” Archives of Environmental Contamination and Toxicology 23: 468-472.
Mamdouh, A.-Z. and E. Zahran “Mycotoxins and their impact on human and animal health.”
Marroquín-Cardona, A., N. Johnson, T. Phillips and A. Hayes (2014). “Mycotoxins in a changing global environment–a review.” Food and Chemical Toxicology 69: 220-230.
Maslowski, K. M. and C. R. Mackay (2011). “Diet, gut microbiota and immune responses.” Nature immunology 12(1): 5-9.
Mishra, H. and C. Das (2003). “A review on biological control and metabolism of aflatoxin.”
Mohsenzadeh, M. S., N. Hedayati, B. Riahi-Zanjani and G. Karimi (2016). “Immunosuppression following dietary aflatoxin B1 exposure: a review of the existing evidence.” Toxin Reviews 35(3-4): 121-127.
Müller, H. M., C. Lerch, K. Müller and W. Eggert (1998). “Kinetic profiles of ochratoxin A and ochratoxin α during in vitro incubation in buffered forestomach and abomasal contents from cows.” Natural Toxins 6(6): 251-258.
Neal, G., D. Eaton, D. Judah and A. Verma (1998). “Metabolism and toxicity of aflatoxins M1and B1in human-derivedin VitroSystems.” Toxicology and applied pharmacology 151(1): 152-158.
Negash, D. (2018). “A review of aflatoxin: occurrence, prevention, and gaps in both food and feed safety.” Journal of Applied Microbiological Research 1(1): 35-43.
Oakley, B. B., H. S. Lillehoj, M. H. Kogut, W. K. Kim, J. J. Maurer, A. Pedroso, M. D. Lee, S. R. Collett, T. J. Johnson and N. A. Cox (2014). “The chicken gastrointestinal microbiome.” FEMS microbiology letters 360(2): 100-112.
Omotayo, O. P., A. O. Omotayo, M. Mwanza and O. O. Babalola (2019). “Prevalence of mycotoxins and their consequences on human health.” Toxicological research 35(1): 1-7.
Parent-Massin, D. (2004). “Haematotoxicity of trichothecenes.” Toxicology letters 153(1): 75-81.
Payros, D., I. Alassane-Kpembi, A. Pierron, N. Loiseau, P. Pinton and I. P. Oswald (2016). “Toxicology of deoxynivalenol and its acetylated and modified forms.” Archives of toxicology 90: 2931-2957.
Payros, D., U. Dobrindt, P. Martin, T. Secher, A. P. F. Bracarense, M. Boury, J. Laffitte, P. Pinton, E. Oswald and I. P. Oswald (2017). “The food contaminant deoxynivalenol exacerbates the genotoxicity of gut microbiota.” MBio 8(2): 10.1128/mbio. 00007-00017.
Peng, Z., Y. Liao, L. Chen, S. Liu, Z. Shan, A. K. Nüssler, P. Yao, H. Yan, L. Liu and W. Yang (2019). “Heme oxygenase-1 attenuates low-dose of deoxynivalenol-induced liver inflammation potentially associating with microbiota.” Toxicology and Applied Pharmacology 374: 20-31.
Pestka, J. J. (2010). “Deoxynivalenol: mechanisms of action, human exposure, and toxicological relevance.” Archives of toxicology 84(9): 663-679.
Pinton, P., D. Tsybulskyy, J. Lucioli, J. Laffitte, P. Callu, F. Lyazhri, F. Grosjean, A. P. Bracarense, M. Kolf-Clauw and I. P. Oswald (2012). “Toxicity of deoxynivalenol and its acetylated derivatives on the intestine: differential effects on morphology, barrier function, tight junction proteins, and mitogen-activated protein kinases.” Toxicological Sciences 130(1): 180-190.
Proctor, R. H., S. P. McCormick, H.-S. Kim, R. E. Cardoza, A. M. Stanley, L. Lindo, A. Kelly, D. W. Brown, T. Lee and M. M. Vaughan (2018). “Evolution of structural diversity of trichothecenes, a family of toxins produced by plant pathogenic and entomopathogenic fungi.” PLoS pathogens 14(4): e1006946.
Puri, S., S. Shingh and P. Tiwari (2019). “Mycotoxins: A Threat to Food Security and Health.” International Journal of Applied Sciences and Biotechnology 7(3): 298-303.
Rao, K. R., A. Vipin, P. Hariprasad, K. A. Appaiah and G. Venkateswaran (2017). “Biological detoxification of Aflatoxin B1 by Bacillus licheniformis CFR1.” Food Control 71: 234-241.
Rieswijk, L., S. M. Claessen, O. Bekers, M. van Herwijnen, D. H. Theunissen, D. G. Jennen, T. M. de Kok, J. C. Kleinjans and S. G. van Breda (2016). “Aflatoxin B1 induces persistent epigenomic effects in primary human hepatocytes associated with hepatocellular carcinoma.” Toxicology 350: 31-39.
Rogowska, A., P. Pomastowski, G. Sagandykova and B. Buszewski (2019). “Zearalenone and its metabolites: Effect on human health, metabolism and neutralisation methods.” Toxicon 162: 46-56.
Rotimi, O. A., S. O. Rotimi, C. U. Duru, O. J. Ebebeinwe, A. O. Abiodun, B. O. Oyeniyi and F. A. Faduyile (2017). “Acute aflatoxin B1–Induced hepatotoxicity alters gene expression and disrupts lipid and lipoprotein metabolism in rats.” Toxicology reports 4: 408-414.
Schatzmayr, G., D. Heidler, E. Fuchs, E. Binder, A. Loibner and R. Braun (2002). “Evidence of ochratoxin A-detoxification activity of rumen fluid, intestinal fluid and soil samples as well as isolation of relevant microorganisms from these environments.” Mycotoxin Research 18(Suppl 2): 183-187.
Sekirov, I., S. L. Russell, L. C. M. Antunes and B. B. Finlay (2010). “Gut microbiota in health and disease.” Physiological reviews.
Stiborová, M., V. M. Arlt and H. H. Schmeiser (2016). “Balkan endemic nephropathy: an update on its aetiology.” Archives of toxicology 90(11): 2595-2615.
Taheur, F. B., K. Fedhila, K. Chaieb, B. Kouidhi, A. Bakhrouf and L. Abrunhosa (2017). “Adsorption of aflatoxin B1, zearalenone and ochratoxin A by microorganisms isolated from Kefir grains.” International journal of food microbiology 251: 1-7.
Tan, H., Z. Zhang, Y. Hu, L. Wu, F. Liao, J. He, B. Luo, Y. He, Z. Zuo and Z. Ren (2015). “Isolation and characterization of Pseudomonas otitidis TH-N1 capable of degrading Zearalenone.” Food Control 47: 285-290.
Taranu, I., C. Braicu, D. E. Marin, G. C. Pistol, M. Motiu, L. Balacescu, I. B. Neagoe and R. Burlacu (2015). “Exposure to zearalenone mycotoxin alters in vitro porcine intestinal epithelial cells by differential gene expression.” Toxicology Letters 232(1): 310-325.
Upadhaya, S. D., J. Y. Song, M. A. Park, J. K. Seo, L. Yang, C. H. Lee, K. J. Cho and J. K. Ha (2012). “Isolation, screening and identification of swine gut microbiota with ochratoxin A biodegradation ability.” Asian-Australasian journal of animal sciences 25(1): 114.
Vignal, C., M. Djouina, M. Pichavant, S. Caboche, C. Waxin, D. Beury, D. Hot, C. Gower-Rousseau and M. Body-Malapel (2018). “Chronic ingestion of deoxynivalenol at human dietary levels impairs intestinal homeostasis and gut microbiota in mice.” Archives of Toxicology 92: 2327-2338.
Wang, J.-J., R.-Q. Zhang, Q.-Y. Zhai, J.-C. Liu, N. Li, W.-X. Liu, L. Li and W. Shen (2019). “Metagenomic analysis of gut microbiota alteration in a mouse model exposed to mycotoxin deoxynivalenol.” Toxicology and applied pharmacology 372: 47-56.
Wang, J., F. Yang, P. Yang, J. Liu and Z. Lv (2018). “Microbial reduction of zearalenone by a new isolated Lysinibacillus sp. ZJ-2016-1.” World Mycotoxin Journal 11(4): 571-578.
Wang, L., J. Wu, Z. Liu, Y. Shi, J. Liu, X. Xu, S. Hao, P. Mu, F. Deng and Y. Deng (2019). “Aflatoxin B1 degradation and detoxification by Escherichia coli CG1061 isolated from chicken cecum.” Frontiers in Pharmacology 9: 1548.
Wang, S., W. Fu, X. Zhao, X. Chang, H. Liu, L. Zhou, J. Li, R. Cheng, X. Wu and X. Li (2022). “Zearalenone disturbs the reproductive-immune axis in pigs: The role of gut microbial metabolites.” Microbiome 10(1): 234.
Wang, W., S. Zhai, Y. Xia, H. Wang, D. Ruan, T. Zhou, Y. Zhu, H. Zhang, M. Zhang and H. Ye (2019). “Ochratoxin A induces liver inflammation: involvement of intestinal microbiota.” Microbiome 7: 1-14.
Wang, Y., W. Zheng, X. Bian, Y. Yuan, J. Gu, X. Liu, Z. Liu and J. Bian (2014). “Zearalenone induces apoptosis and cytoprotective autophagy in primary Leydig cells.” Toxicology letters 226(2): 182-191.
Xia, D., L. Yang, Y. Li, J. Chen, X. Zhang, H. Wang, S. Zhai, X. Jiang, G. Meca and S. Wang (2021). “Melatonin alleviates Ochratoxin A-induced liver inflammation involved intestinal microbiota homeostasis and microbiota-independent manner.” Journal of Hazardous Materials 413: 125239.
Xu, P., S. Dong, X. Luo, B. Wei, C. Zhang, X. Ji, J. Zhang, X. Zhu, G. Meng and B. Jia (2023). “Humic acids alleviate aflatoxin B1-induced hepatic injury by reprogramming gut microbiota and absorbing toxin.” Ecotoxicology and Environmental Safety 259: 115051.
Xu, X., J. Chang, P. Wang, C. Liu, M. Liu, T. Zhou, Q. Yin and G. Yan (2023). “Combination of glycyrrhizic acid and compound probiotics alleviates deoxynivalenol-induced damage to weaned piglets.” Ecotoxicology and Environmental Safety 256: 114901.
Yang, S., L. Li, L. Yu, L. Sun, K. Li, C. Tong, W. Xu, G. Cui, M. Long and P. Li (2020). “Selenium-enriched yeast reduces caecal pathological injuries and intervenes changes of the diversity of caecal microbiota caused by Ochratoxin-A in broilers.” Food and Chemical Toxicology 137: 111139.
Yang, S., Y. Wang, R. C. Beier, H. Zhang, K. D. Ruyck, F. Sun, X. Cao, J. Shen, S. Zhang and Z. Wang (2015). “Simultaneous determination of type A and B trichothecenes and their main metabolites in food animal tissues by ultraperformance liquid chromatography coupled with triple-quadrupole mass spectrometry.” Journal of agricultural and food chemistry 63(38): 8592-8600.
Young, J. C., T. Zhou, H. Yu, H. Zhu and J. Gong (2007). “Degradation of trichothecene mycotoxins by chicken intestinal microbes.” Food and Chemical Toxicology 45(1): 136-143.
Yuan, T., J. Li, Y. Wang, M. Li, A. Yang, C. Ren, D. Qi and N. Zhang (2022). “Effects of Zearalenone on Production Performance, Egg Quality, Ovarian Function and Gut Microbiota of Laying Hens.” Toxins 14(10): 653.
Zhai, X., Z. Qiu, L. Wang, Y. Luo, W. He and J. Yang (2022). “Possible toxic mechanisms of deoxynivalenol (DON) exposure to intestinal barrier damage and dysbiosis of the gut microbiota in laying hens.” Toxins 14(10): 682.
Zhang, F.-L., H.-H. Ma, P.-Y. Dong, Y.-M. C. Yan, Y. Chen, G.-M. Yang, W. Shen and X.-F. Zhang (2024). “Bacillus licheniformis ameliorates Aflatoxin B1-induced testicular damage by improving the gut-metabolism-testis axis.” Journal of Hazardous Materials 468: 133836.
Zhang, H., A. Yan, X. Liu, Y. Ma, F. Zhao, M. Wang, J. J. Loor and H. Wang (2021). “Melatonin ameliorates ochratoxin A induced liver inflammation, oxidative stress and mitophagy in mice involving in intestinal microbiota and restoring the intestinal barrier function.” Journal of Hazardous Materials 407: 124489.
Zhang, J., L. You, W. Wu, X. Wang, Z. Chrienova, E. Nepovimova, Q. Wu and K. Kuca (2020). “The neurotoxicity of trichothecenes T-2 toxin and deoxynivalenol (DON): Current status and future perspectives.” Food and Chemical Toxicology 145: 111676.
Zhang, W., S. Zhang, J. Wang, A. Shan and L. Xu (2020). “Changes in intestinal barrier functions and gut microbiota in rats exposed to zearalenone.” Ecotoxicology and Environmental Safety 204: 111072.
Zhang, Y., S. Choi, K. Nogoy and S. Liang (2021). Review: The development of the gastrointestinal tract microbiota and intervention in neonatal ruminants. Animal 15, 100316.